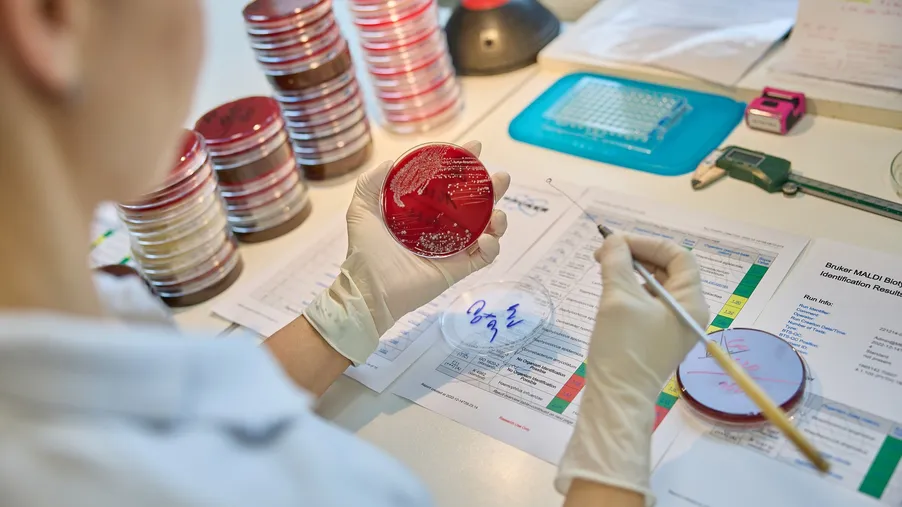

Mikrobiologie novinky
Vážení kolegové, dovolujeme si Vás informovat o rozšíření počtu akreditovaných metod o detekci protilátek proti hepatitidě E (anti-HEV IgM a anti-HEV IgG). Mění se pro Vás něco? Pro Vás jako žadatele o vyšetření se nic nemění.
Vážení kolegové,
dovolujeme si Vás informovat o rozšíření počtu akreditovaných metod o detekci protilátek proti hepatitidě E (anti-HEV IgM a anti-HEV IgG).
Mění se pro Vás něco? Pro Vás jako žadatele o vyšetření se nic nemění.
Vyšetření provádíme v pracovní dny nebo ve statimovém režimu denně ze séra nebo z plasmy. V případě zjištění pozitivity protilátek v třídě IgM provádíme pro odlišení probíhající a proběhlé infekce PCR detekci nukleové kyseliny viru HEV.
Vzorky séra nebo plasmy můžete zasílat stále tak, jak jste zvyklí.
Akreditace metody zvyšuje nároky pouze na nás jako laboratoř, na kvalitu naší práce, čímž zajišťuje vysokou kvalitu vydávaných výsledků pro Vás lékaře a Vaše pacienty.
V případě dotazů nás neváhejte kontaktovat.
Těšíme se na úspěšnou spolupráci v roce 2026!
prim. MUDr. Eva Vítová
Oddělení lékařské mikrobiologie a imunologie
Oblastní nemocnice Trutnov a.s.
---------------------



